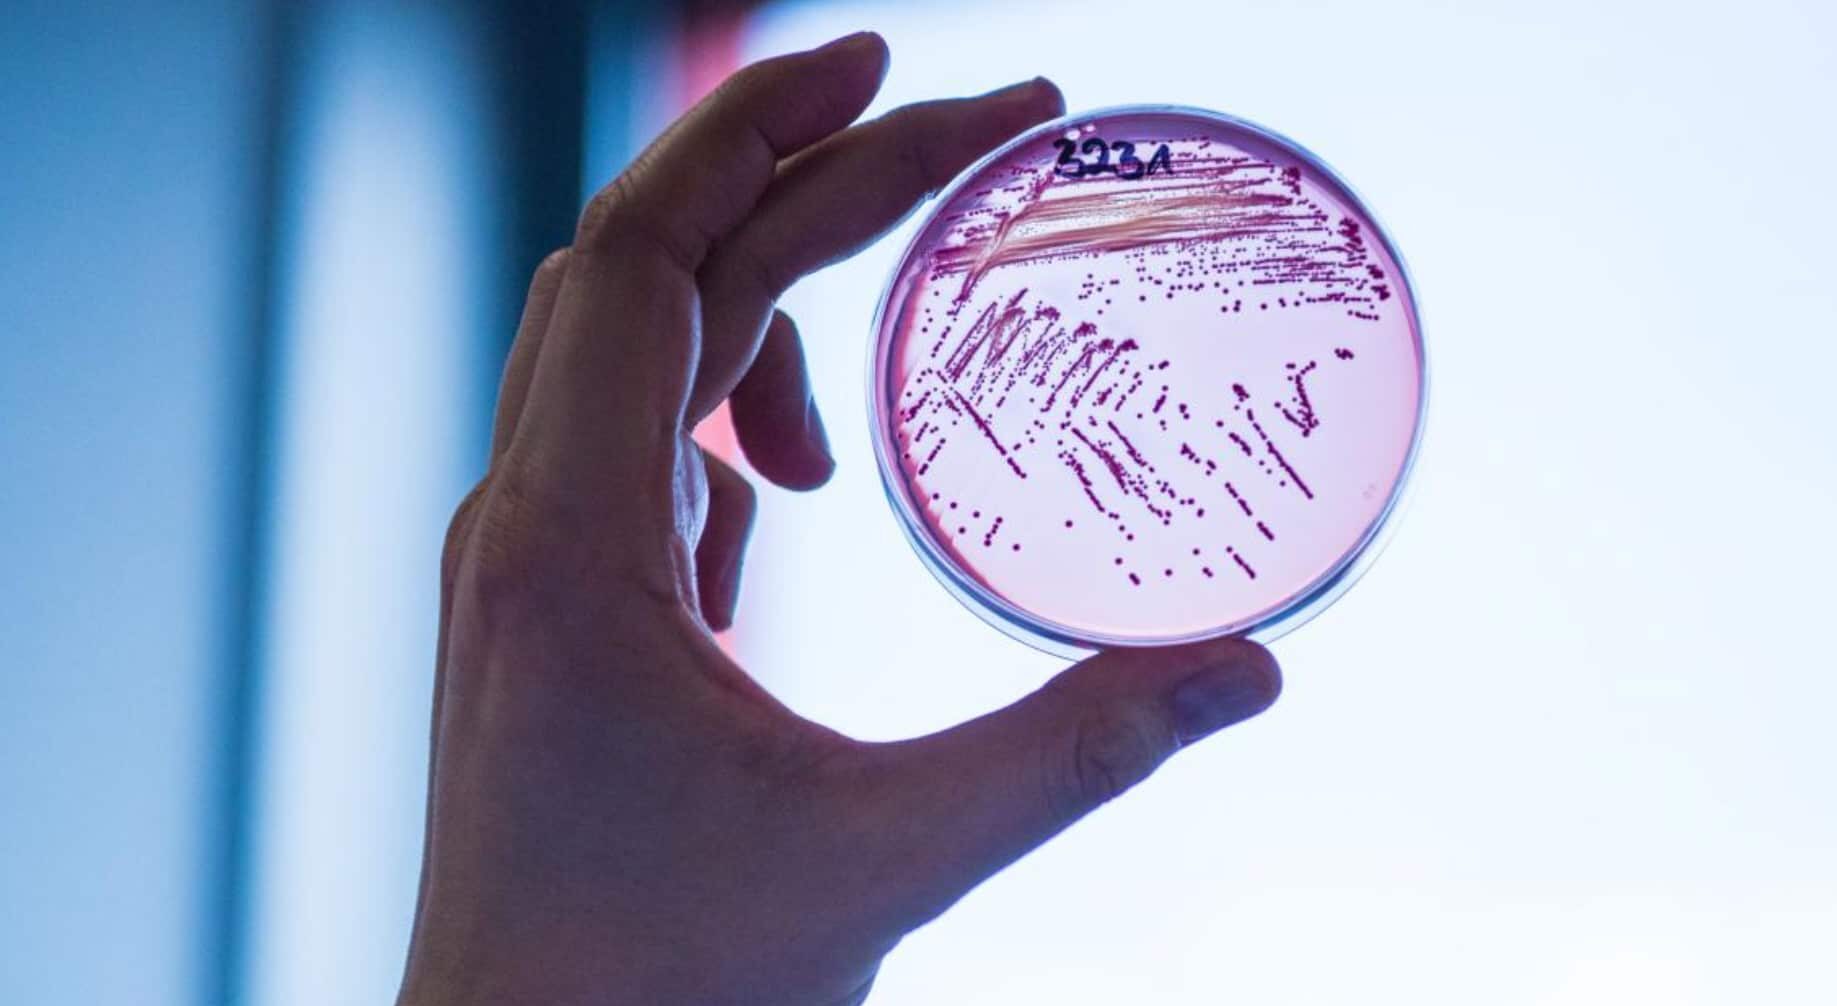

ΣΥΜΒΑΙΝΕΙ ΤΩΡΑ
-
Καταδίωξη στο Μοσχάτο: Χειροπέδες σε 18χρονο και 16χρονο που επέβαιναν σε κλεμμένη μοτοσικλέτα
-
Οργισμένη αντίδραση της Μόσχας στην κατάληψη του ρωσικού τάνκερ από το γαλλικό Ναυτικό στον Ατλαντικό
-
Μπανέ Εμπαγιέ: Η χυμώδης Dj χορεύει με «καυτό» μαύρο μπικίνι κι ανεβάζει απότομα την θερμοκρασία – Δείτε βίντεο
-
«Πουλάει τρελίτσα» ο Ε.Ράμα για το διάβημα του ελληνικού ΥΠΕΞ: «Δεν ήξερα ότι υπάρχουν Έλληνες εκεί»
-
Σύγκρουση σκαφών στη Μαρίνα Ζέας: Τουριστικό έπεσε πάνω σε αλιευτικό – Ολοκληρωτική καταστροφή του ψαροκάικου
-
Γάμος Αμαλίας Κωστοπούλου: Όταν ο πατέρας της Πέτρος και ο Β.Κικίλιας αντάλλαξαν βλοσυρές ματιές
-
Έπεσαν πυροβολισμοί στα Δεμένικα Πάτρας: Τραυματίστηκε ένα άτομο
-
Κοπάδι δελφινιών σε παραλία της Εύβοιας προκάλεσε έκπληξη στους λουόμενους – Δείτε το βίντεο
-
Η ανάρτηση της Αλεξάνδρας Παλαιολόγου με μαγιό για να ευχηθεί καλό μήνα στους followers της(φωτο)
-
Μεγάλη αστυνομική επιχείρηση στη Θεσσαλονίκη: Έλεγχοι σε δεκάδες ανήλικα κι επτά καταστήματα
Το βακτήριο klebsiella pneumoniae (κλεμπσιέλλα), είναι συνήθως αβλαβή και συχνά ζει στο έντερο χωρίς να δημιουργεί κανένα πρόβλημα, ωστόσο μπορεί να είναι επικίνδυνο εάν εισέλθει σε άλλα μέρη του σώματός σας, ειδικά εάν είστε ήδη άρρωστοι.
Τα εν λόγω βακτήρια μπορούν να μετατραπούν σε “υπερβακτήρια” που είναι σχεδόν αδύνατο να καταπολεμηθούν με κοινά αντιβιοτικά. Μπορεί να οδηγήσουν σε πνευμονία, να μολύνουν την πληγή ή το αίμα και να προκαλέσουν άλλα σοβαρά προβλήματα.
Ποιοι κινδυνεύουν περισσότερο
Οι λοιμώξεις είναι σπάνιες σε υγιείς ανθρώπους, επειδή το ανοσοποιητικό τους σύστημα είναι αρκετά ισχυρό ώστε να αποκρούει τα βακτήρια. Αλλά οι λοιμώξεις είναι πιο πιθανές εάν έχετε προβλήματα υγείας όπως:
- Αλκοολισμός
- Καρκίνος
- Διαβήτης
- Νεφρική ανεπάρκεια
- Ηπατική νόσος
- Πνευμονική νόσος
Η λήψη ορισμένων αντιβιοτικών για μεγάλο χρονικό διάστημα ή άλλες θεραπείες μπορεί επίσης να αυξήσει τις πιθανότητές σας για λοίμωξη από klebsiella.
Πώς μεταδίδεται το klebsiella pneumoniae
Αυτά τα μικρόβια δεν μεταδίδονται μέσω του αέρα. Απαιτείται άμεση επαφή για να αρρωστήσετε. Ένας τρόπος θα ήταν να αγγίξετε ένα κόψιμο στο δέρμα σας με βρώμικα χέρια.
Οι περισσότερες μολύνσεις συμβαίνουν σε νοσοκομεία, γηροκομεία και άλλα μέρη με πολλούς άρρωστους. Τα μικρόβια μπορούν επίσης να εξαπλωθούν όταν μπουν σε ιατρικές συσκευές όπως:
- ενδοφλέβιοι καθετήρες
- ενδοτραχειακοί σωλήνες και αναπνευστήρες
- ουρικοί καθετήρες
Τα συμπτώματα
Αυτά εξαρτώνται από το πού βρίσκεται η μόλυνση. Για παράδειγμα, εάν τα βακτήρια σας προκαλούν πνευμονία, μπορεί να έχετε τα εξής:
- Πυρετός
- Βήχας
- Πόνος στο στήθος
- Πρόβλημα αναπνοής
- Περισσότερη βλέννα, η οποία μπορεί να είναι παχιά και αιματηρή
Το βακτήριο klebsiella pneumoniae μπορεί να πλήξει και άλλα μέρη του σώματος. Για παράδειγμα, μια χειρουργική πληγή μπορεί να έχει μολυνθεί. Είναι επίσης πιθανό να προκληθεί λοίμωξη σε:
- Αίμα (βακτηριαιμία ή σηψαιμία)
- Εγκέφαλο (μηνιγγίτιδα)
- Καρδιά (ενδοκαρδίτιδα)
- Δέρμα (κυτταρίτιδα)
- Ουροποιητικό σύστημα (ουρολοιμώξεις)
Εάν εσείς ή κάποιο αγαπημένο σας πρόσωπο έχετε σημάδια μόλυνσης, μιλήστε με τον γιατρό σας. Τα συμπτώματα από μόνα τους δεν μπορούν να πουν εάν η αιτία είναι το klebsiella pneumoniae.
Η θεραπεία
Οι λοιμώξεις από klebsiella pneumoniae μπορεί να είναι επικίνδυνες, επομένως οι γιατροί ξεκινούν τη θεραπεία με αντιβιοτικά αμέσως. Παραδείγματα περιλαμβάνουν κεφαλοσπορίνες (κεφοταξίμη και κεφτριαξόνη) και καρβαπενέμες (ιμιπενέμη ή σιλαστατίνη).
Εάν ο γιατρός σας συνταγογραφήσει αντιβιοτικά, πάρτε τα ακριβώς όπως ορίζει η ετικέτα στην συσκευασία. Εάν σταματήσετε να τα παίρνετε πολύ σύντομα, η μόλυνση μπορεί να επανέλθει.
Εάν έχετε μια ανθεκτική στα αντιβιοτικά λοίμωξη, ο γιατρός σας θα αποφασίσει τον καλύτερο τρόπο θεραπείας. Πιθανότατα θα δοκιμάσει έναν διαφορετικό τύπο αντιβιοτικού ή έναν συνδυασμό τους.
Οι περισσότεροι που έχουν λοίμωξη από klebsiella pneumoniae αναρρώνουν. Αλλά ορισμένες περιπτώσεις μπορεί να είναι θανατηφόρες, ειδικά η πνευμονία σε άτομα που είναι ήδη πολύ άρρωστα.
Πρόληψη
Ένας από τους καλύτερους τρόπους για να προστατευτείτε είναι απλός. Να πλένετε πάντα τα χέρια σας προτού:
- Γευματίσετε
- Αγγίξετε τα μάτια, την μύτη ή το στόμα σας
- Αλλάξτε τους επιδέσμους σε ένα κόψιμο

































Tο pronews.gr δημοσιεύει κάθε σχόλιο το οποίο είναι σχετικό με το θέμα στο οποίο αναφέρεται το άρθρο. Ο καθένας έχει το δικαίωμα να εκφράζει ελεύθερα τις απόψεις του. Ωστόσο, αυτό δεν σημαίνει ότι υιοθετούμε τις απόψεις αυτές και διατηρούμε το δικαίωμα να μην δημοσιεύουμε συκοφαντικά ή υβριστικά σχόλια όπου τα εντοπίζουμε. Σε κάθε περίπτωση ο καθένας φέρει την ευθύνη των όσων γράφει και το pronews.gr ουδεμία νομική ή άλλα ευθύνη φέρει.
Δικαίωμα συμμετοχής στη συζήτηση έχουν μόνο όσοι έχουν επιβεβαιώσει το email τους στην υπηρεσία disqus. Εάν δεν έχετε ήδη επιβεβαιώσει το email σας, μπορείτε να ζητήσετε να σας αποσταλεί νέο email επιβεβαίωσης από το disqus.com
Όποιος χρήστης της πλατφόρμας του disqus.com ενδιαφέρεται να αναλάβει διαχείριση (moderating) των σχολίων στα άρθρα του pronews.gr σε εθελοντική βάση, μπορεί να στείλει τα στοιχεία του και στοιχεία επικοινωνίας στο info3@pronews.gr και θα εξεταστεί άμεσα η υποψηφιότητά του.